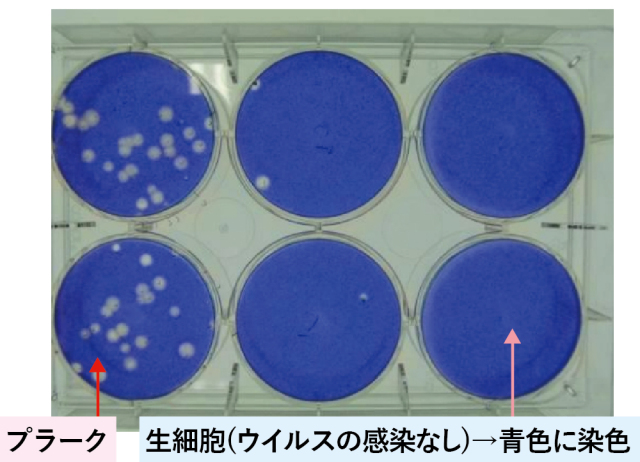

商品紹介
抗ウイルス加工「ウイルスナックス」


「SEKマーク」シリーズは、繊維製品における抗ウイルス性試験方法の国際基準ISO18184に準拠したもので、「ウイルスナックス」には株式会社マルゼンの「抗ウイルス繊維製品」が使用されています。
(特許番号 第6689613号)

SEK抗ウイルス加工とは
~繊維状の特定のウイルスの数を減少させる加工です~
昨今、各種のウイルスによる被害が社会問題となり、複数の繊維メーカーから抗ウイルス加工繊維製品が販売されています。しかし、抗ウイルス性試験方法が各社により異なり、その効果が不明確なため、統一規格が求められていました。そこで、繊技協が中心となって国際標準化を開始し、2014年にISO18184(繊維製品の抗ウイルス性試験方法)が国際標準として発行されました。
その一方で、繊技協はこの事業と並行してマーク制度の準備を行い、2015年4月から、抗ウイルス加工マークの認証を開始しました。繊技協では、抗ウイルス加工の目的を、「繊維製品に付着したウイルスの数を減少させて清潔に保つことにある」としています。そのため、抗ウイルス加工マーク繊維製品は、ウイルスの働きを抑制したり、病気の治療や予防をしたりするもではありません。
抗ウイルス性の評価基準
試験方法と試験基準は、JIS L1922(繊維製品の抗ウイルス性試験方法)に従っています。
この試験方法では、抗ウイルス効果を表す指標に抗ウイルス活性値が採用されています。
抗ウイルス活性値は、標準布と抗ウイルス加工布のそれぞれにウイルスを接種して25℃で2時間放置し、ウイルス数の常用対数の差で表します。

抗ウイルス感染価の測定方法(JIS L1922 13項)
その値が3.0以上であればウイルスの数が千分の1以下に減少したことを示します。

抗ウイルス効果(JIS L1922附属書 G)
JIS L1922では、この抗ウイルス活性値が3.0以上で十分な効果を示すと定められており、繊技協の抗ウイルス加工マークでは、この数値を評価基準としています。

JIS L1922(繊維製品の抗ウイルス性試験方法)
この試験方法は、ISO18184「繊維製品の抗ウイルス性試験方法」がJIS化されたものです。
ISO規格には、日本のNPO法人バイオメディカルサイエンス研究会、(一財)日本繊維製品品質技術センターおよび繊技協が共同開発した試験方法が採用されています。
抗ウイルス加工マークの評価には、プラーク法を採用しています。
プラーク法
※プラークとは
ウイルスの感染によって生体染色が行えなくなった細胞の部分であり、変性を起こした細胞は色素を保持しないので、周囲の変性を受けていない細胞の青色をバックに色素を欠く斑点として認められる。インフルエンザウイルス、ネコカリシウイルスは、プラークを形成するウイルス種である。
また、試験対象ウイルスは、ウイルスの構造の違いより選択されています。

ウイルスの構造
ウイルスにはエンベローブ(envelope)と呼ばれる、主に脂質でできた膜状の構造があるものとないものがあります。
エンベローブがあるものとしてはインフルエンザウイルスを、ないものとしてはネコカリシウイルスを採用しています。

試験対象ウイルスと宿主細胞(JIS L1922 附属所 A)
これらは、バイオセーフティレベルが2であり、取り扱いのしやすさが考慮されています。
インフルエンザなどの病気の予防を消費者に暗示させることを避けるため、試験対象ウイルス名は、抗ウイルス加工繊維製品や販促物などに付与するマークや注意表示に記載することを禁止しています。
商品紹介
消費税込33,000円

商品仕様
| サイズ | 幅:150㎝ 長さ:210㎝ |
|---|---|
| 生地 | 綿100% ダウンプルーフ加工(抗ウイルス加工) |
| 中綿 | ホワイトダックダウン70% スモールフェザー30% 1.4kg |
| 加工 | ヨーロッパキルト |

消費税込28,000円

商品仕様
| サイズ | 幅:150㎝ 長さ:210㎝ |
|---|---|
| 生地 | 綿100% ダウンプルーフ加工(抗ウイルス加工) |
| 中綿 | ポリエステル特殊つぶわた加工 1.8kg |
| 加工 | ヨーロッパキルト |

消費税込16,000円

商品仕様
| サイズ | 幅:150㎝ 長さ:210㎝ |
|---|---|
| 生地 | 綿100% ダウンプルーフ加工(抗ウイルス加工) |
| 中綿 | ウォッシャブルポリエステルわた 1.6kg |
| 加工 | 額市松キルト |

消費税込13,000円

商品仕様
| サイズ | 幅:150㎝ 長さ:210㎝ |
|---|---|
| 生地 | 綿100% ダウンプルーフ加工(抗ウイルス加工) |
| 中綿 | ウォッシャブルポリエステルわた 0.6kg |
| 加工 | 額市松キルト |

消費税込33,000円

商品仕様
| サイズ | 幅:100㎝ 長さ:210㎝ |
|---|---|
| 生地 | 綿100% ダウンプルーフ加工(抗ウイルス加工) |
| 中芯 | 35mmプロファイルウレタン(凹凸加工) 1.2kg ポリエステル固綿1.5kg |
| 巻き綿 | 羊毛混1.6kg |
| 加工 | ダイヤ・ハシゴキルト |

消費税込48,000円

商品仕様
| サイズ | 幅:100㎝ 長さ:210㎝ |
|---|---|
| 生地 | 綿100% ダウンプルーフ加工(抗ウイルス加工) |
| 中芯 | 60mmプロファイルウレタン(凹凸加工) 2.5kg |
| 巻き綿 | 羊毛混2.5kg |
| 加工 | マジックベルト付き・多頭キルト |

消費税込6,000円

商品仕様
| サイズ | 幅:63㎝ 長さ:43㎝ |
|---|---|
| 生地 | 綿100% ダウンプルーフ加工(抗ウイルス加工) |
| 中ワタ | スモールフェザー1.2kg |

消費税込8,000円

商品仕様
| サイズ | 幅:63㎝ 長さ:43㎝ |
|---|---|
| 生地 | 綿100% ダウンプルーフ加工(抗ウイルス加工) |
| 中ワタ | ダウンエッセンスつぶわた 650g |

消費税込10,000円

商品仕様
| サイズ | 幅:63㎝ 長さ:43㎝ |
|---|---|
| 生地 | 綿100% ダウンプルーフ加工(抗ウイルス加工) |
| 中ワタ | ダウン30% フェザー70% 700g |










